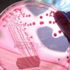

MORE IN SAĞLIK»
resimsiz
Kayıp kampçılara ulaşıldı
06 Kasım 2017 19:49 resimsizGalatasaraylı Maicon Türk kültürünü keşfe çıktı
06 Kasım 2017 19:49 resimsizİşten çıkarıldı, açlık grevine başlayacak
06 Kasım 2017 14:58 resimsizBeşiktaş'ta divan kurulu toplantısı Cumartesi günü
06 Kasım 2017 14:58
Dört gen pankreas kanserinde hayatta kalma şansını etkiliyor
06 Kasım 2017 11:47
Yaşam süresini uzatan egzersiz
06 Kasım 2017 11:47 resimsizDünya Kupası'nda duvar boyuyordu, şimdi Premier Lig'i sallıyor
06 Kasım 2017 10:55
Kış geldi diye grip olmak zorunda değilsiniz
06 Kasım 2017 08:46
‘Vitastiq’ isimli tıbbi cihaz Sağlık Bakanlığı tarafından yasakl…
06 Kasım 2017 08:46 resimsizKandilli Rasathanesi Müdürü Prof. Özener: Marmara'da 2 metrelik …
06 Kasım 2017 06:46WHAT'S NEW IN SAĞLIK»
- Pfizer'ın koronavirüs hapı için lisans anlaş…
- Belçika'da aşı yaptırmayan sağlık personelin…
- Kepez DokumaPark'ta botanik bahçe açıldı
- Kayapınar Belediyesi'ne ‘TS EN ISO 9001 Kali…
- Manisa'da prestij cadde düzenlemeleri sürüyor
- Serik'te trafik kazası : 3 yaralı
- Karantinayı ihlal eden 2 kişi trafik uygulam…
- Kıbrıs Gazisi Yılmaz son yolculuğuna uğurlan…
- Ormanda üzerine ağaç devrilen Hakan öldü
- Burcu Esmersoy'un akşam yemeği şıklığı
- Pfizer, Kovid-19'a karşı ağızdan alınan ilaç…
- Covid-19'a yakalanan hamilelerde erken doğum…
- AB Adalet Divanı'ndan yargı bağımsızlığı kon…
- Doğumu kolaylaştıran yeni teknik literatüre …
- Sivas'ta doğumu kolaylaştıran teknik: Bilim …
- Türkiye'nin koronavirüs aşılama kampanyası k…
- Corona aşısından sonra sıra kanserde
- Koronavirüs erken doğum riskini arttırıyor
- "Fazla dezenfektan cilt kuruluğuna neden olu…
- Bilim Kurulu üyesinden 3. doz açıklaması!